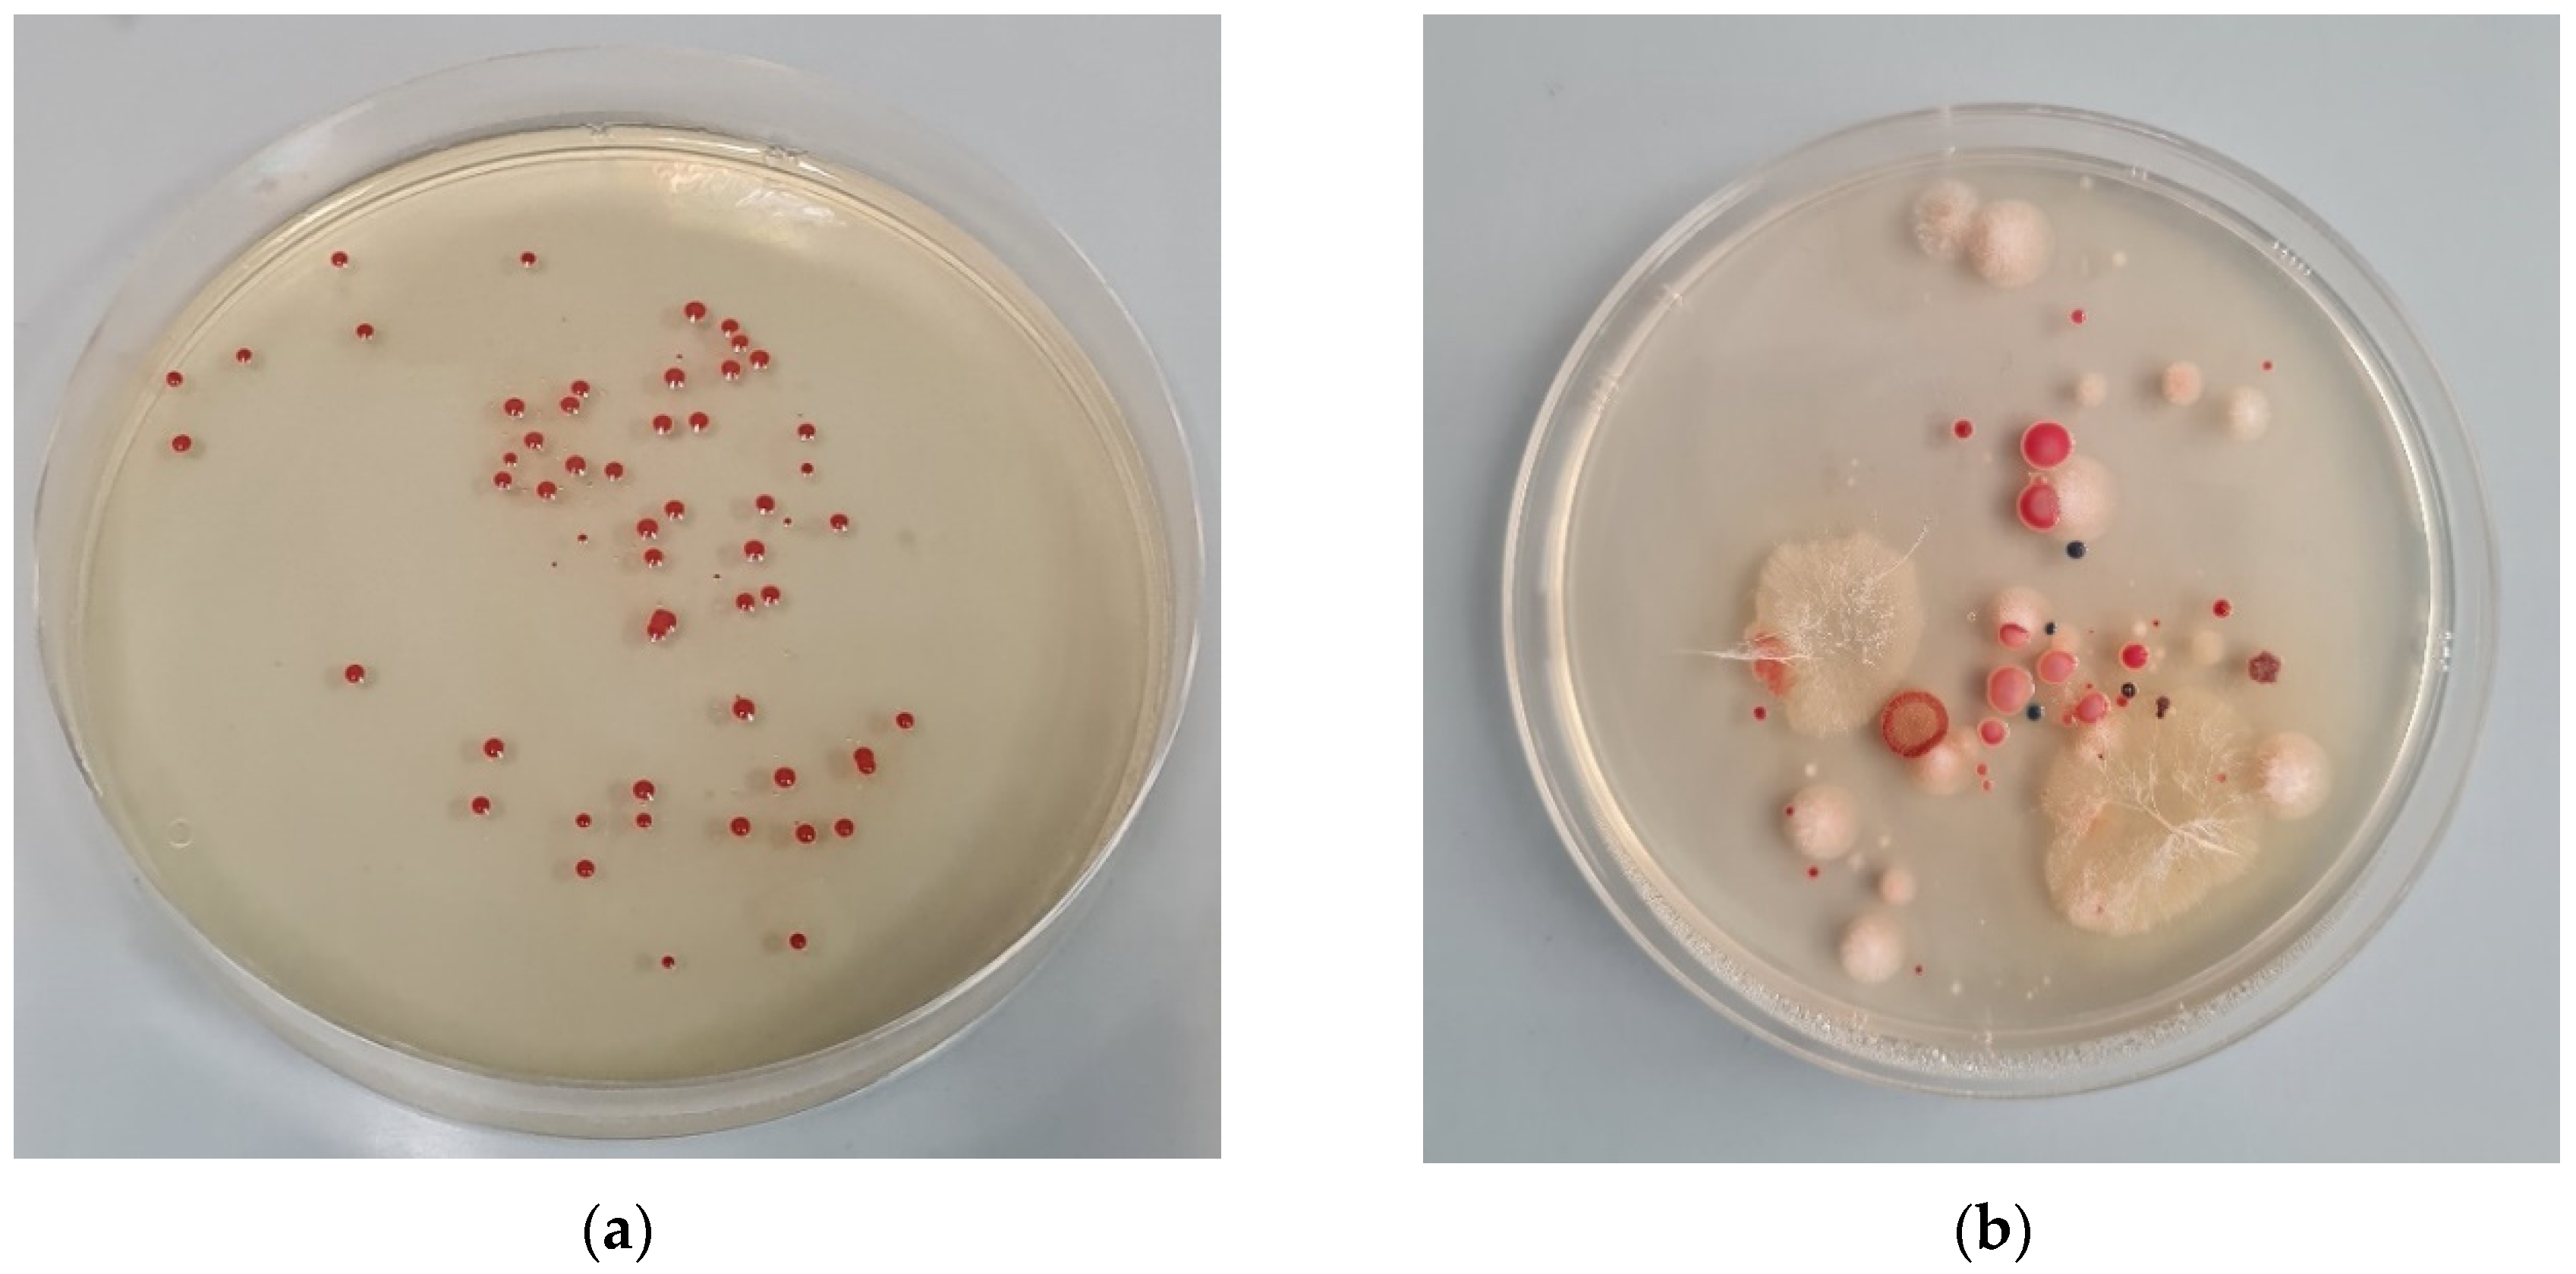
Fire 06 00155 g003

Short-Term Effects of Experimental Fire on Physicochemical and Microbial Properties of a Mediterranean Cambisol
Abstract
:1. Introduction
2. Materials and Methods
2.1. Study Area
2.2. Experimental Design and Field Sampling
2.3. Analyses of Physical Parameters
2.4. Analyses of Chemical Parameters
2.5. Mineralogical Analyses
2.6. Bacteriological Analyses
2.7. Statistical Analyses
3. Results
3.1. Post-Fire Meteorological Observation
3.2. Soil Physical Properties
3.3. Soil Chemical Properties
3.4. Soil Mineralogical Properties
3.5. Soil Microbial Properties
3.6. Multivariate Analysis
4. Discussion
5. Conclusions
Author Contributions
Funding
Institutional Review Board Statement
Informed Consent Statement
Data Availability Statement
Conflicts of Interest
Appendix A

References
- Certini, G. Effects of fire on properties of forest soils: A review. Oecologia 2005, 143, 1–10. [Google Scholar] [CrossRef]
- Moghli, A.; Santana, V.M.; Baeza, M.J.; Pastor, E.; Soliveres, S. Fire Recurrence and Time Since Last Fire Interact to Determine the Supply of Multiple Ecosystem Services by Mediterranean Forests. Ecosystems 2022, 25, 1358–1370. [Google Scholar] [CrossRef]
- Sáenz de Miera, L.E.; Pinto, R.; Gutierrez-Gonzalez, J.J.; Calvo, L.; Ansola, G. Wildfire effects on diversity and composition in soil bacterial communities. Sci. Total Environ. 2020, 726, 138636. [Google Scholar] [CrossRef] [PubMed]
- Ferran, A.; Delitti, W.; Vallejo, V.R.; De Estudios, C.; Darwin, C.C.R.; Tecnologic, P. Effects of Fire Recurrence in Quercus coccifera L. Shrublands of the Valencia Region (Spain): II. Plant and Soil Nutrients. Plant Ecol. 2017, 177, 71–83. [Google Scholar] [CrossRef]
- Clarke, P.J.; Lawes, M.J.; Midgley, J.J.; Lamont, B.B.; Ojeda, F.; Burrows, G.E.; Enright, N.J.; Knox, K.J.E. Resprouting as a key functional trait: How buds, protection and resources drive persistence after fire. New Phytol. 2013, 197, 19–35. [Google Scholar] [CrossRef] [Green Version]
- Muñoz-Rojas, M.; Erickson, T.E.; Martini, D.; Dixon, K.W.; Merritt, D.J. Soil physicochemical and microbiological indicators of short, medium and long term post-fire recovery in semi-arid ecosystems. Ecol. Indic. 2016, 63, 14–22. [Google Scholar] [CrossRef]
- Pausas, J.G.; Fernández-Muñoz, S. Fire regime changes in the Western Mediterranean Basin: From fuel-limited to drought-driven fire regime. Clim. Chang. 2012, 110, 215–226. [Google Scholar] [CrossRef] [Green Version]
- Knicker, H. How does fire affect the nature and stability of soil organic nitrogen and carbon? A review. Biogeochemistry 2007, 85, 91–118. [Google Scholar] [CrossRef]
- Reich, P.B.; Peterson, D.W.; Wedin, D.A.; Wrage, K. Fire and vegetation effects on productivity and nitrogen cycling across a forest-grassland continuum. Ecology 2001, 82, 1703–1719. [Google Scholar] [CrossRef]
- Guénon, R.; Vennetier, M.; Dupuy, N.; Roussos, S.; Pailler, A.; Gros, R. Trends in recovery of mediterranean soil chemical properties and microbial activities after infrequent and frequent wildfires. Land Degrad. Dev. 2013, 24, 115–128. [Google Scholar] [CrossRef] [Green Version]
- Trasar-Cepeda, C.; Leirós, M.C.; Gil-Sotres, F. Hydrolytic enzyme activities in agricultural and forest soils. Some implications for their use as indicators of soil quality. Soil Biol. Biochem. 2008, 40, 2146–2155. [Google Scholar] [CrossRef] [Green Version]
- Nannipieri, P.; Ascher, J.; Ceccherini, M.T.; Landi, L.; Pietramellara, G.; Renella, G. Microbial diversity and soil functions. Eur. J. Soil Sci. 2003, 54, 655–670. [Google Scholar] [CrossRef]
- Nelson, A.R.; Narrowe, A.B.; Rhoades, C.C.; Fegel, T.S.; Daly, R.A.; Roth, H.K.; Chu, R.K.; Amundson, K.K.; Geonczy, S.E.; Emerson, J.B.; et al. Playing with FiRE: A genome resolved view of the soil microbiome responses to high severity forest wildfire. biorXiv 2021, 8. [Google Scholar] [CrossRef]
- Lombao, A.; Barreiro, A.; Fontúrbel, M.T.; Martín, A.; Carballas, T.; Díaz-Raviña, M. Key factors controlling microbial community responses after a fire: Importance of severity and recurrence. Sci. Total Environ. 2020, 741, 140363. [Google Scholar] [CrossRef]
- Kottek, M.; Grieser, J.; Beck, C.; Rudolf, B.; Rubel, F. World map of the Köppen-Geiger climate classification updated. Meteorol. Z. 2006, 15, 259–263. [Google Scholar] [CrossRef]
- IUSS-WRB. World Reference Base for Soil Resources 2014, Update 2015: International Soil Classification System for Naming Soils and Creating Legends for Soil Maps; World Soil Resources Reports No. 106; Food and Agriculture Organization of the United Nations: Rome, Italy, 2015. [Google Scholar]
- Doerr, S.H.; Blake, W.H.; Shakesby, R.A.; Stagnitti, F.; Vuurens, S.H.; Humphreys, G.S.; Wallbrink, P. Heating effects on water repellency in Australian eucalypt forest soils and their value in estimating wildfire soil temperatures. Int. J. Wildland Fire 2004, 13, 157–163. [Google Scholar] [CrossRef]
- Kemper, W.D.; Rosenau, R.C. Aggregate stability and size distribution. Methods Soil Anal. Part A Phys. Mineral. Methods 1986, 5, 425–442. [Google Scholar]
- Walkley, A.; Black, I.A. An examination of the Degtjareff method for determining soil organic matter, and a proposed modification of the chromic acid titration method. Soil Sci. 1934, 37, 29–38. [Google Scholar] [CrossRef]
- Mehra, O.P.; Jackson, M.L. Iron oxides removal from soils and clays by a dithionite–citrate–bicarbonate system buffered with sodium bicarbonate. In Proceedings of the 7th National Conference on Clays and Clay Minerals, Washington, DC, USA, 20–23 October 1958; pp. 317–327. [Google Scholar]
- Schwertmann, U. Differenzierung der Eisenoxide des Bodens durch Extraktion mit saurer Ammoniumoxalat-Lösung. Z. Pflanz. Dung. Bodenkd. 1964, 105, 194–202. [Google Scholar] [CrossRef]
- Norouz, M.; Ramezanpour, H. Effect of Fire on Chemical Forms of Iron and Manganese in Forest Soils of Iran. Environ. Forensics 2013, 14, 169–177. [Google Scholar] [CrossRef]
- Casida, L.E.; Klein, D.A.; Thomas, S. Soil dehydrogenase activity. Soil Sci. 1964, 98, 371–376. [Google Scholar] [CrossRef]
- Arcenegui, V.; Mataix-Solera, J.; Guerrero, C.; Zornoza, R.; Mataix-Beneyto, J.; García-Orenes, F. Immediate effects of wildfires on water repellency and aggregate stability in Mediterranean calcareous soils. Catena 2008, 74, 219–226. [Google Scholar] [CrossRef]
- Delač, D.; Kisić, I.; Bogunović, I.; Pereira, P. Temporal impacts of pile burning on vegetation regrowth and soil properties in a Mediterranean environment (Croatia). Sci. Total Environ. 2021, 799, 149318. [Google Scholar] [CrossRef] [PubMed]
- de Jonge, L.W.; Jacobsen, O.H.; Moldrup, P. Soil Water Repellency: Effects of Water Content, Temperature, and Particle Size. Soil Sci. Soc. Am. J. 1999, 63, 437–442. [Google Scholar] [CrossRef]
- Giovannini, G.; Lucchesi, S. Modifications Induced in Soil Physico-Chemical Parameters by Experimental Fires at Different Intensities. Soil Sci. 1997, 162, 479–486. [Google Scholar] [CrossRef]
- Andreu, V.; Imeson, A.C.; Rubio, J.L. Temporal changes in soil aggregates and water erosion after a wildfire in a Mediterranean pine forest. Catena 2001, 44, 69–84. [Google Scholar] [CrossRef] [Green Version]
- Oswald, B.P.; Davenport, D.; Neuenschwander, L.F. Effects of slash pile burning on the physical and chemical soil properties of Vassar soils. J. Sustain. For. 1999, 8, 75–86. [Google Scholar] [CrossRef]
- Neary, D.G.; Ryan, K.C.; DeBano, L.F. Wildland Fire in Ecosystems: Effects of Fire on Soils and Water; Gen Tech Rep RMRS-GTR-42-vol.4; US Department of Agriculture, Forest Service, Rocky Mountain Research Station: Ogden, UT, USA, 2005; 250p. [Google Scholar] [CrossRef] [Green Version]
- Pereira, P.; Brevik, E.; Bogunović, I.; Ferran, E.-S. Ash and Soils: A Close Relationship in Fire-Affected Areas. In Fire Effects on Soil Properties; Pereira, P., Mataix-Solera, J., Úbeda, X., Rein, G., Cerdà, A., Eds.; CSIRO Publishing: Clayton South, VIC, Australia, 2019. [Google Scholar] [CrossRef]
- Francos, M.; Úbeda, X.; Pereira, P.; Alcañiz, M. Long-term impact of wildfire on soils exposed to different fire severities. A case study in Cadiretes Massif (NE Iberian Peninsula). Sci. Total Environ. 2018, 615, 664–671. [Google Scholar] [CrossRef] [PubMed]
- Murphy, J.D.; Johnson, D.W.; Miller, W.W.; Walker, R.F.; Carroll, E.F.; Blank, R.R. Wildfire Effects on Soil Nutrients and Leaching in a Tahoe Basin Watershed. J. Environ. Qual. 2006, 35, 479–489. [Google Scholar] [CrossRef] [Green Version]
- Rossetti, I.; Cogoni, D.; Calderisi, G.; Fenu, G. Short-Term Effects and Vegetation Response after a Megafire in a Mediterranean Area. Land 2022, 11, 2328. [Google Scholar] [CrossRef]
- Caon, L.; Vallejo, V.R.; Coen, R.J.; Geissen, V. Effects of wildfire on soil nutrients in Mediterranean ecosystems. Earth Sci. Rev. 2014, 139, 47–58. [Google Scholar] [CrossRef]
- Pereira, P.; Úbeda, X.; Martin, D.; Mataix-Solera, J.; Guerrero, C. Effects of a low severity prescribed fire on water-soluble elements in ash from a cork oak (Quercus suber) forest located in the northeast of the Iberian Peninsula. Environ. Res. 2011, 111, 237–247. [Google Scholar] [CrossRef] [PubMed]
- Mataix-Solera, J.; Guerrero, C.; García-Orenes, F.; Bárcenas, G.M.; Torres, M.P. Forest Fire Effects on Soil Microbiology. In Fire Effects on Soils and Restoration Strategies; CRC Press: Boca Raton, FL, USA, 2009; pp. 149–192. [Google Scholar] [CrossRef]
- Vázquez, F.J.; Acea, M.J.; Carballas, T. Soil microbial populations after wildfire. FEMS Microbiol. Ecol. 1993, 13, 93–103. [Google Scholar] [CrossRef] [Green Version]
- Grassol, G.M.; Ripabellil, G.; Sammarcol, M.L.; Mazzoleni, S. Effects of Heating on the Microbial Populations of a Grassland Soil. Int. J. Wildl. Fire 1996, 6, 67–70. [Google Scholar] [CrossRef]
- Dunn, P.H.; Barro, S.C.; Poth, M. Soil moisture affects survival of microorganisms in heated chaparral soil. Soil Biol. Biochem. 1985, 17, 143–148. [Google Scholar] [CrossRef]
- Dunn, P.H.; DeBano, L.F.; Eberlein, G.E. Effects of burning on chaparral soils: II. Soil microbes and nitrogen mineralisation. Soil Sci. Soc. Am. J. 1979, 43, 509–514. [Google Scholar] [CrossRef]
- Bárcenas-Moreno, G.; García-Orenes, F.; Mataix-Solera, J.; Mataix-Beneyto, J.; Bååth, E. Soil microbial recolonization after a fire in a Mediterranean forest. Biol. Fertil. Soils 2011, 47, 261–272. [Google Scholar] [CrossRef]
- Paul, C.; Filippidou, S.; Jamil, I.; Kooli, W.; House, G.L.; Estoppey, A.; Hayoz, M.; Junier, T.; Palmieri, F.; Wunderlin, T.; et al. Bacterial Spores, from Ecology to Biotechnology, 1st ed.; Advances in Applied Microbiology; Elsevier Inc.: Amsterdam, The Netherlands, 2019. [Google Scholar] [CrossRef]
- Smith, N.R.; Kishchuk, B.E.; Mohn, W.W. Effects of wildfire and harvest disturbances on forest soil bacterial communities. Appl. Environ. Microbiol. 2008, 74, 216–224. [Google Scholar] [CrossRef] [PubMed] [Green Version]
- Manian, S.; Paulsamy, S.; Senthilkumar, K.; Kil, B.-S. Impact of Surface Fire on the Dynamics of N 2—Fixing and P—Solubilizing Microbial Population in Natural Grassland Soils, Southern India. Korean J. Ecol. 2002, 25, 227–234. [Google Scholar] [CrossRef] [Green Version]
- Djenadi, K.; Zhang, L.; Murray, A.K.; Gaze, W.H. Carbapenem resistance in bacteria isolated from soil and water environments in Algeria. J. Glob. Antimicrob. Resist. 2018, 15, 262–267. [Google Scholar] [CrossRef]
- Hrenovic, J.; Ivankovic, T.; Durn, G.; Dekic, S.; Kazazic, S.; Kisic, I. Presence of carbapenem-resistant bacteria in soils affected by illegal waste dumps. Int. J. Environ. Health Res. 2019, 29, 154–163. [Google Scholar] [CrossRef] [PubMed] [Green Version]
- Lopez, N.V.; Farsar, C.J.; Harmon, D.E.; Ruiz, C. Urban and agricultural soils in Southern California are a reservoir of carbapenem-resistant bacteria. Microbiologyopen 2020, 9, 1247–1263. [Google Scholar] [CrossRef] [PubMed] [Green Version]
- Hrenovic, J.; Ganjto, M.; Goic-Barisic, I. Carbapenem-resistant bacteria in a secondary wastewater treatment plant. Water SA 2017, 43, 186–191. [Google Scholar] [CrossRef] [Green Version]
- Lucas-Borja, M.E.; Ortega, R.; Miralles, I.; Plaza-Álvarez, P.A.; González-Romero, J.; Peña-Molina, E.; Moya, D.; Zema, D.A.; Wagenbrenner, J.W.; de las Heras, J. Effects of wildfire and logging on soil functionality in the short-term in Pinus halepensis M. forests. Eur. J. For. Res. 2020, 139, 935–945. [Google Scholar] [CrossRef]
- Memoli, V.; Panico, S.C.; Santorufo, L.; Barile, R.; Di Natale, G.; Di Nunzio, A.; Toscanesi, M.; Trifuoggi, M.; De Marco, A.; Maisto, G. Do wildfires cause changes in soil quality in the short term? Int. J. Environ. Res. Public Health 2020, 17, 5343. [Google Scholar] [CrossRef] [PubMed]
- Singh, D.; Sharma, P.; Kumar, U.; Daverey, A.; Arunachalam, K. Effect of forest fire on soil microbial biomass and enzymatic activity in oak and pine forests of Uttarakhand Himalaya, India. Ecol. Process. 2021, 10, 29. [Google Scholar] [CrossRef]
- Plaza-Álvarez, P.A.; Moya, D.; Lucas-Borja, M.E.; García-Orenes, F.; González-Romero, J.; Rossa, C.; Peña, E.; De las Heras, J. Early spring prescribed burning in mixed Pinus halepensis Mill. and Pinus pinaster Ait. stands reduced biological soil functionality in the short term. Land Degrad. Dev. 2021, 32, 1312–1324. [Google Scholar] [CrossRef]
- Moya, D.; González-De Vega, S.; García-Orenes, F.; Morugán-Coronado, A.; Arcenegui, V.; Mataix-Solera, J.; Lucas-Borja, M.E.; De las Heras, J. Temporal characterisation of soil-plant natural recovery related to fire severity in burned Pinus halepensis Mill. forests. Sci. Total Environ. 2018, 640–641, 42–51. [Google Scholar] [CrossRef] [PubMed]
- Santín, C.; Doerr, S.H. Fire effects on soils: The human dimension. Philos. Trans. R. Soc. B Biol. Sci. 2016, 371, 20150171. [Google Scholar] [CrossRef] [Green Version]

| Soil Fraction | T | Sampling Occasion | Friedman | ||||
|---|---|---|---|---|---|---|---|
| IAF | 1MAF | 2MAF | 4MAF | 6MAF | p | ||
| Composite | C | 2.22 ± 0.46 b | 2.33 ± 1.09 b | 2.25 ± 0.49 | 2.31 ± 0.41 | 2.67 ± 1.18 | n.s. |
| F | 13.39 ± 5.12 Aa | 7.22 ± 2.02 Ba | 2.22 ± 0.47 B | 2.87 ± 0.39 B | 3.17 ± 0.9 B | *** | |
| K–W p | *** | ** | n.s. | n.s. | n.s. | ||
| 1–2 mm | C | 2.33 ± 0.43 | 1.08 ± 0.07 | 2.42 ± 0.28 | 1.99 ± 0.25 | 1.05 ± 0.87 b | n.s. |
| F | 2.28 ± 0.62 | 2.89 ± 0.63 | 2.01 ± 0.24 | 2.31 ± 0.23 | 2.75 ± 0.64 a | n.s. | |
| K–W p | n.s. | *** | n.s. | n.s. | * | ||
| 0.5–1 mm | C | 3.44 ± 0.37 | 1.06 ± 0.08 b | 2.42 ± 0.43 | 2.01 ± 0.01 | 1.2 ± 0.07 b | n.s. |
| F | 3.78 ± 1.26 A | 2.5 ± 0.92 Ba | 2.01 ± 0.33 B | 2.11 ± 0.02 B | 2.08 ± 0.83 Ba | * | |
| K–W p | n.s. | *** | n.s. | n.s. | * | ||
| 0.25–0.5 mm | C | 3.08 ± 0.4 Ab | 1.04 ± 0.02 Cb | 2.42 ± 0.14 B | 2.31 ± 0.13 B | 1.02 ± 0.03 Cb | *** |
| F | 5.06 ± 1.75 Aa | 2.78 ± 1.31 Ba | 2.17 ± 0.29 B | 2.16 ± 0.11 B | 2.33 ± 0.78 Ba | * | |
| K–W p | *** | ** | n.s. | n.s. | * | ||
| <0.25 mm | C | 3.09 ± 0.6 Ab | 1.01 ± 0.03 Bb | 2.83 ± 0.69 A | 2.67 ± 0.8 A | 1.03 ± 0.03 Bb | ** |
| F | 14.22 ± 1.47 Aa | 7.44 ± 1.15 Ba | 3.42 ± 0.86 C | 2.55 ± 0.72 C | 3.02 ± 0.41 Ca | * | |
| K–W p | *** | *** | n.s. | n.s. | *** | ||
| Variable | T | Sampling Occasion | Friedman | ||||
|---|---|---|---|---|---|---|---|
| IAF | 1MAF | 2MAF | 4MAF | 6MAF | p | ||
| MWD (mm) | C | 1.56 ± 0.09 Bb | 1.52 ± 0.15 Bb | 1.68 ± 0.16 ABb | 1.71 ± 0.15 ABb | 1.95 ± 0.1 A | ** |
| F | 2.37 ± 0.27 Aa | 2.50 ± 0.23 Aa | 2.17 ± 0.11 ABa | 2.19 ± 0.17 ABa | 1.87 ± 0.23 B | *** | |
| K–W p | ** | ** | * | * | n.s. | ||
| WSA (%) | C | 61.8 ± 2.57 ABb | 57.07 ± 4.08 Bb | 66.88 ± 8.13 AB | 67.87 ± 7.61 AB | 71.06 ± 1.19 A | ** |
| F | 83.52 ± 4.91 Aa | 75.72 ± 8.99 ABa | 76.28 ± 4.56 AB | 72.03 ± 6.71 AB | 68.38 ± 5.88 B | * | |
| K–W p | ** | ** | n.s. | n.s. | n.s. | ||
| Variable | T | Sampling Occasion | F | ||||
|---|---|---|---|---|---|---|---|
| IAF | 1MAF | 2MAF | 4MAF | 6MAF | p | ||
| pH | C | 6.59 ± 0.14 B | 6.93 ± 0.16 A | 6.83 ± 0.13 ABb | 6.73 ± 0.11 ABb | 6.70 ± 0.05 ABb | ** |
| F | 6.62 ± 0.27 C | 7.19 ± 0.07 B | 7.53 ± 0.13 ABa | 7.51 ± 0.11 ABa | 7.68 ± 0.06 Aa | *** | |
| K–W p | n.s. | n.s. | * | ** | ** | ||
| EC (μS cm−1) | C | 107.6 ± 6.27 Ab | 146.3 ± 10.3 Ab | 81.18 ± 7.03 Bb | 82.1 ± 6.71 Bb | 86.38 ± 8.22 Bb | *** |
| F | 176.65 ± 36.5 Ba | 291.33 ± 60.3 Aa | 194.3 ± 14.14 ABa | 198 ± 5.31 Aa | 194.9 ± 13.9 ABa | *** | |
| K–W p | ** | *** | *** | ** | *** | ||
| TC (%) | C | 4.21 ± 0.55 Ba | 5.93 ± 0.66 Aa | 4.18 ± 0.45 B | 4.11 ± 0.31 B | 4.61 ± 0.36 Ba | *** |
| F | 4 ± 0.23 Ab | 3.91 ± 0.33 Ab | 3.63 ± 0.31 AB | 3.51 ± 0.29 AB | 3.31 ± 0.22 Bb | * | |
| K–W p | * | *** | n.s. | n.s. | * | ||
| TN (%) | C | 0.42 ± 0.04 Ba | 0.5 ± 0.07 Aa | 0.37 ± 0.04 B | 0.36 ± 0.01 B | 0.38 ± 0.02 Ba | * |
| F | 0.31 ± 0.2 Ab | 0.34 ± 0.03 Ab | 0.32 ± 0.03 AB | 0.31 ± 0.01 B | 0.28 ± 0.02 Bb | * | |
| K–W p | ** | *** | n.s. | n.s. | ** | ||
| C/N | C | 10.02 ± 0.37 Bb | 11.88 ± 0.33 A | 11.41 ± 0.1 AB | 11.43 ± 0.1 AB | 12.11 ± 0.59 A | *** |
| F | 12.09 ± 0.18 Aa | 11.55 ± 0.24 A | 11.47 ± 0.47 A | 11.45 ± 0.3 A | 11.61 ± 0.29 A | n.s. | |
| K–W p | ** | n.s. | n.s. | n.s. | n.s. | ||
| TS (%) | C | 0.10 ± 0.01 Bb | 0.12 ± 0.01 Aa | 0.10 ± 0.01 B | 0.10 ± 0.02 B | 0.10 ± 0.01 Ba | ** |
| F | 0.11 ± 0.13 Aa | 0.10 ± 0.01 ABb | 0.11 ± 0.01 A | 0.10 ± 0.01 AB | 0.08 ± 0.01 Bb | ** | |
| K–W p | * | ** | n.s. | n.s. | ** | ||
| Variable | T | Sampling Occasion | Friedman | ||||
|---|---|---|---|---|---|---|---|
| IAF | 1MAF | 2MAF | 4MAF | 6MAF | p | ||
| THB (CFU/g) | C | 7.5 × 106 Ba | 1.8 × 107 ABa | 2.4 × 107 ABa | 3.4 × 107 A | 3.0 × 107 Ab | ** |
| F | 9.9 × 105 Bb | 2.9 × 106 Bb | 1.1 × 107 Bb | 4.9 × 107 A | 6.1 × 107 Aa | *** | |
| K–W p | *** | *** | ** | n.s. | ** | ||
| SB (CFU/g) | C | 2.0 × 106 Ba | 4.9 × 106 Aa | 3.8 × 106 AB | 2.2 × 106 Bb | 2.3 × 106 Bb | ** |
| F | 5.8 × 105 Cb | 1.1 × 106 BCb | 4.3 × 106 AB | 5.4 × 106 Aa | 6.0 × 106 Aa | *** | |
| K–W p | ** | ** | n.s. | * | * | ||
| PSB (CFU/g) | C | 7.4 × 105 Ba | 1.7 × 106 Ba | 5.0 × 106 A | 5.4 × 106 A | 6.3 × 106 A | *** |
| F | 3.2 × 104 Bb | 3.6 × 105 Bb | 5.4 × 106 A | 5.7 × 106 A | 6.4 × 106 A | ** | |
| K–W p | *** | *** | n.s. | n.s. | n.s. | ||
| CB (CFU/g) | C | 2.5 × 103 Ba | 1.5 × 104 Aa | 3.2 × 103 ABa | 2.3 × 103 B | 1.1 × 104 B | *** |
| F | ˂1 Cb | ˂1 Cb | 5.5 × 102 Bb | 1.3 × 103 A | 2.9 × 103 A | *** | |
| K–W p | * | * | * | n.s. | n.s. | ||
| DA (A485nm) | C | 0.157 | 0.283 a | 0.27 | 0.209 | 0.113 | n.s. |
| F | 0.079 B | 0.145 ABb | 0.107 AB | 0.196 A | 0.127 AB | * | |
| K–W p | n.s. | * | n.s. | n.s. | n.s. | ||
Disclaimer/Publisher’s Note: The statements, opinions and data contained in all publications are solely those of the individual author(s) and contributor(s) and not of MDPI and/or the editor(s). MDPI and/or the editor(s) disclaim responsibility for any injury to people or property resulting from any ideas, methods, instructions or products referred to in the content. |
© 2023 by the authors. Licensee MDPI, Basel, Switzerland. This article is an open access article distributed under the terms and conditions of the Creative Commons Attribution (CC BY) license (https://creativecommons.org/licenses/by/4.0/).
Share and Cite
Hrenović, J.; Kisić, I.; Delač, D.; Durn, G.; Bogunović, I.; Mikulec, M.; Pereira, P. Short-Term Effects of Experimental Fire on Physicochemical and Microbial Properties of a Mediterranean Cambisol. Fire 2023, 6, 155. https://doi.org/10.3390/fire6040155
Hrenović J, Kisić I, Delač D, Durn G, Bogunović I, Mikulec M, Pereira P. Short-Term Effects of Experimental Fire on Physicochemical and Microbial Properties of a Mediterranean Cambisol. Fire. 2023; 6(4):155. https://doi.org/10.3390/fire6040155
Chicago/Turabian StyleHrenović, Jasna, Ivica Kisić, Domina Delač, Goran Durn, Igor Bogunović, Mateja Mikulec, and Paulo Pereira. 2023. "Short-Term Effects of Experimental Fire on Physicochemical and Microbial Properties of a Mediterranean Cambisol" Fire 6, no. 4: 155. https://doi.org/10.3390/fire6040155
APA StyleHrenović, J., Kisić, I., Delač, D., Durn, G., Bogunović, I., Mikulec, M., & Pereira, P. (2023). Short-Term Effects of Experimental Fire on Physicochemical and Microbial Properties of a Mediterranean Cambisol. Fire, 6(4), 155. https://doi.org/10.3390/fire6040155








